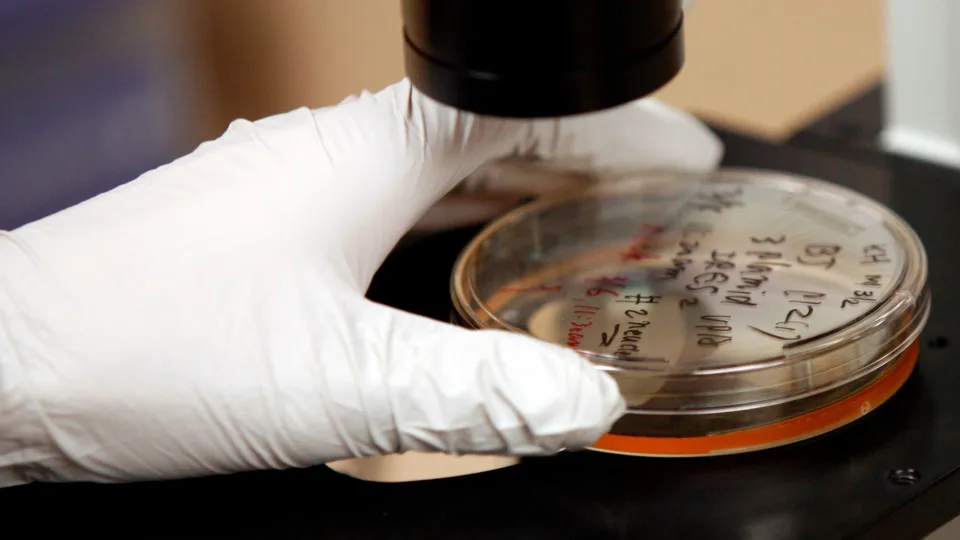

Falta pouco para a chegada de uma nova lua cheia. Enquanto isso, estamos passando por outra fase importante do ciclo lunar. Nesta sexta-feira, ocorre uma lua nova em Áries, que traz uma energia intensa e pode impactar diretamente alguns signos do zodíaco. Será que você está entre eles?
De acordo com o site Oh La Lá, quatro signos tendem a sentir mais os efeitos desse momento. Embora existam pontos positivos, também surgem desafios que merecem atenção. Veja se o seu signo está na lista e o que esperar nos próximos dias.
Áries (21 de março a 20 de abril)
“Este é o seu novo nascimento astral, e impacta em tudo: identidade, corpo, desejos, direção. A concentração de planetas que o acompanha, incluindo o seu planeta regente Marte, além de Saturno, Mercúrio e Netuno, torna este um dos momentos mais importantes do seu ano. Lembre-se de que, há um ano, o eclipse no seu signo plantou algo novo dentro de si, e hoje essa mudança exige ação concreta. Pode trazer à tona uma antiga ferida relacionada com a sua maneira de existir no mundo, de se afirmar ou de pedir o que precisa. Não a ignore: lidar com faz parte do começo que esta Lua propõe: qual versão de si quer nascer agora?”
Libra (23 de setembro a 22 de outubro)
“Com sete planetas no seu signo oposto, esta Lua Nova impacta diretamente a forma como se conecta com os outros. Toda essa atividade em Áries está acontecendo na sua área de parcerias, relacionamentos e vida amorosa, e também se relaciona com o que o eclipse de março de 2025 despertou. Você ainda está escolhendo os mesmos relacionamentos ou algo mudou na forma como se conecta? O desafio de Libra com Áries, do outro lado, é sempre o mesmo: lembrar que os seus desejos também importam.”
Câncer (21 de junho a 21 de julho)
“A concentração de planetas em Áries ativa a sua área de carreira, reconhecimento e sucesso profissional. Em vez de esperar pelo contexto perfeito ou pela validação externa antes de agir, esta Lua convida você a agir com consistência e equilíbrio, confiando nas suas experiências passadas. A questão é: o que quer construir que seja genuinamente seu? Além disso, pode trazer à tona medos relacionados ao sucesso, à visibilidade ou ao fracasso. Ouça-os, mas não deixe que controlem você.”
Capricórnio (22 de dezembro a 20 de janeiro)
“Esta Lua Nova ativa a sua área do lar, das raízes e da vida familiar. Saturno, o seu planeta regente, está em Áries, o que traz peso e seriedade a esta fase no seu mapa astral. É o momento de plantar seus desejos dentro da família, pois esses compromissos são a base sobre a qual você constrói sua vida. Que estrutura emocional ou familiar deseja manter e qual delas já não representa mais quem você é?”

Publicar comentário